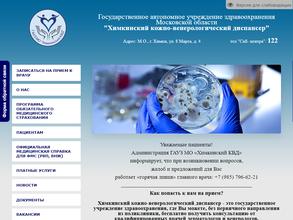
Химкинский кожно-венерологический диспансер

Диспансеры в Химках
Химкинский кожно-венерологический диспансер
Адрес: Химки, Москвина, 4, 1 этаж
Химкинский кожно-венерологический диспансер
Адрес: Химки, 8 Марта, 4, 1 этаж
Наркологический диспансер
г. Химки
Адрес: Химки, Библиотечная, 38
Химкинский Врачебно-Физкультурный Диспансер
Адрес: Химки, Ленинградская, 18а, 4 этаж